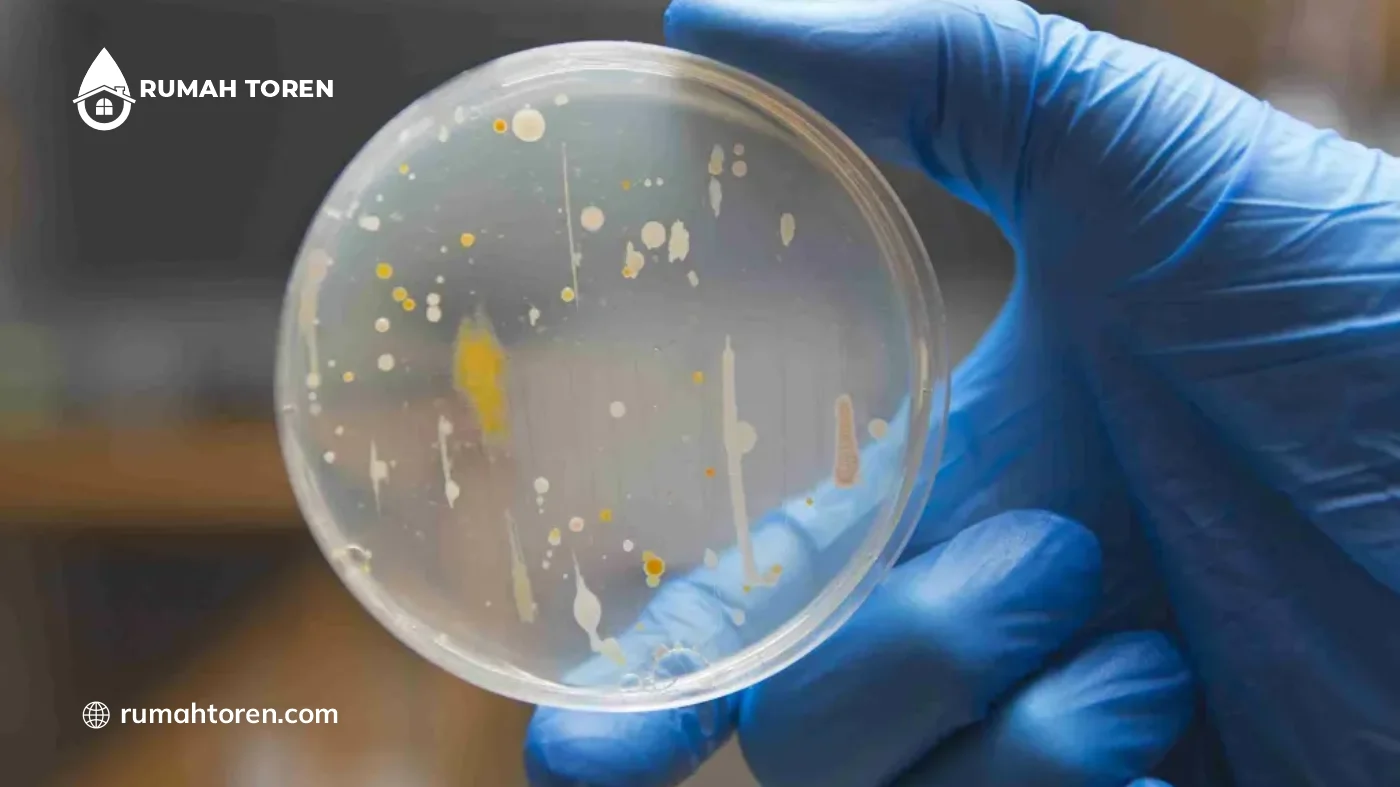
Cara Mudah Deteksi Awal Bakteri Coliform pada Air Toren
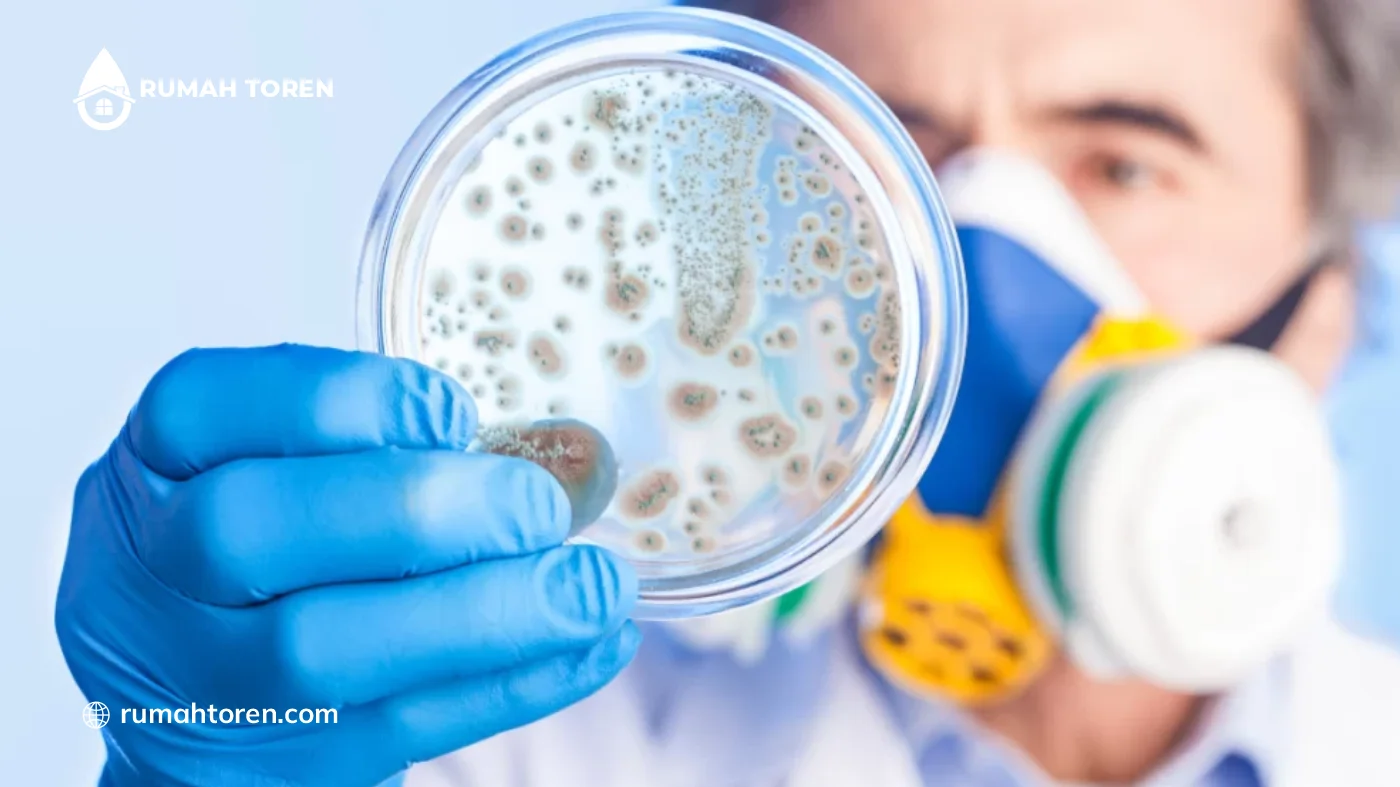
Kenapa Deteksi Bakteri Coliform di Air Toren Sangat Penting?

Deteksi Bakteri Coliform – Kualitas air bersih menjadi faktor penentu utama dalam menciptakan standar kesehatan yang sangat baik.
Toren seringkali menjadi tempat persembunyian berbagai mikroba jahat jika tidak merawatnya dengan rutin.
Setiap pemiliknya wajib mengetahui cara deteksi bakteri Coliform untuk mencegah risiko penyakit yang berbahaya.
Bakteri ini merupakan indikator utama adanya kontaminasi kotoran atau limbah cair yang masuk ke sistem air.
Bahkan, air yang terlihat bening dalam gelas belum tentu aman dari serangan koloni bakteri yang sangat kecil ini.
Penting bagi siapapun untuk menyadari bahwa sumber air tanah atau PDAM tetap berisiko membawa kuman.
Melalui artikel kali ini akan menjelaskan lebih dalam mengenai cara mudah dalam mendeteksi bakteri Coliform pada toren. Jadi, untuk selengkapnya simak artikel berikut.
Cara Mudah Deteksi Awal Bakteri Coliform pada Air Toren
Memastikan kualitas air tetap dalam kondisi sehat merupakan prioritas utama bagi setiap pemilik toren yang peduli terhadap kesejahteraan orang-orang tercinta.
Toren air yang berada pada area terbuka seringkali menjadi sasaran empuk bagi perkembangbiakan mikroba patogen jika sistem penutupnya tidak terjaga dengan rapat.
Oleh karena itu, berikut ini ada beberapa cara mudah untuk deteksi awal bakteri Coliform pada air toren yaitu:
1. Uji Penciuman Aroma Air
Cara pertama adalah mencium aroma air yang keluar dari keran, di mana air yang sehat seharusnya tidak memiliki bau sama sekali.
2. Perhatikan Kejernihan dan Warna Air
Isilah gelas bening dengan air toren dan perhatikan warnanya pada bawah cahaya lampu yang terang untuk melihat tingkat kekeruhan.
Air yang mengandung banyak kuman biasanya tidak akan terlihat kristal bening, melainkan cenderung tampak agak kusam atau memiliki semburat kekuningan.
3. Cek Tekstur Licin atau Lendir
Raba dinding bagian dalam toren atau bagian dalam lubang keran untuk merasakan apakah permukaannya terasa sangat licin atau berlendir.
Jika iya, maka terdapat bakteri pada tempat penampungan tersebut.
4. Amati Munculnya Endapan Lumpur pada Dasar
Gunakan senter untuk melihat bagian dasar toren dan perhatikan apakah terdapat tumpukan lumpur hitam atau sedimen tanah yang tebal.
5. Perhatikan Pertumbuhan Lumut yang Banyak
Periksalah apakah dinding toren sudah tumbuh lumut hijau yang tebal, karena lumut adalah penyedia oksigen dan nutrisi bagi mikroba jahat.
Jika toren penuh dengan lumut, maka secara otomatis kualitas bakteri air tersebut sudah masuk dalam kategori sangat buruk.
6. Gunakan Alat Uji Mandiri
Bisa membeli paket uji bakteri sederhana di toko perlengkapan laboratorium atau toko online yang sangat mudah untuk menggunakannya sendiri.
7. Evaluasi Kesehatan Fisik Penggunanya
Perhatikan apakah ada penggunanya yang sering mengalami keluhan sakit perut, diare, atau gatal-gatal pada kulit setelah mandi.
Jika masalah pencernaan muncul secara berulang, maka segera lakukan pengecekan total pada sanitasi torennya.
8. Periksa Kondisi Segel dan Tutup Toren
Periksalah apakah tutup toren masih terpasang dengan sangat rapat atau sudah mengalami keretakan yang memungkinkan serangga masuk.
Kenapa Deteksi Bakteri Coliform di Air Toren Sangat Penting?
Menjaga kualitas air bersih bukan hanya soal kejernihannya saja, melainkan tentang memastikan air tersebut bebas dari cemaran bakteri yang berbahaya.
Banyak pemilik toren yang sering mengabaikan kondisi mikroba dalam torennya karena merasa sumber airnya sudah terlihat bersih.
Terdapat beberapa alasan tersendiri kenapa deteksi bakteri Coliform pada air toren sangat penting yaitu:
1. Sebagai Indikator Utama Polusi
Alasan pertama adalah karena keberadaan Coliform merupakan sinyal paling akurat bahwa air telah tercemar oleh kotoran manusia atau hewan.
Mendeteksi kuman ini berarti sedang mengecek adanya kebocoran sistem sanitasi yang sangat berbahaya bagi kesehatan.
2. Mencegah Penyakit Saluran Pencernaan
Dengan melakukan deteksi sejak dini, maka bisa segera menghentikan konsumsi air tersebut sebelum bakteri menginfeksi saluran pencernaan penggunanya.
3. Melindungi Sistem Imunitas Anak dan Lansia
Anak-anak dan orang lanjut usia memiliki sistem kekebalan tubuh yang cenderung lebih lemah terhadap serangan infeksi bakteri.
Memastikan air toren bebas dari Coliform sangat penting untuk menjaga agar mereka tidak mudah jatuh sakit secara berulang.
4. Menjamin Higienitas Bahan Makanan
Air toren seringkali menggunakannya untuk mencuci sayuran, buah-buahan, serta perlengkapan makan yang akan bersentuhan langsung dengan mulut. Sehingga pengecekkannya sangatlah penting.
5. Menghindari Risiko Penyakit Kulit dan Mata
Bakteri Coliform tidak hanya menyerang pencernaan namun juga bisa menyebabkan iritasi parah pada area kulit yang sensitif dan selaput mata.
Deteksi dini memastikan air yang bersentuhan dengan tubuh benar-benar aman.
6. Menekan Biaya Pengeluaran Medis
Mengalokasikan waktu untuk memeriksa kualitas air jauh lebih murah daripada membayar tagihan rumah sakit akibat keracunan air yang parah. Deteksi mandiri adalah investasi yang cerdas.
7. Memberikan Rasa Aman dan Ketenangan Pikiran
Mengetahui secara pasti bahwa air bebas dari kuman akan memberikan ketenangan batin bagi setiap penggunanya.
Sehingga tidak perlu merasa waswas atau ragu lagi saat menggunakan air untuk berbagai kebutuhan.
Review Toren Air Grand

Salah satu rekomendasi toren yang cocok untuk penyimpanan air sehari-hari, yaitu dengan menggunakan dari merk Grand.
Tempat penampungan merk Grand sendiri sudah anti bakteri dan anti virus. Sehingga sangat aman untuk penyimpanan air bersih keperluan sehari-hari.
Toren merk Grand sendiri materialnya dari HDPE murni tanpa bahan campuran lain. Hal ini yang menjadikannya memiliki ketahanan sangat bagus dalam menghadapi segala perubahan cuaca ekstrem.
Toren merk Grand juga menjadi yang pertama dan satu-satunya sudah mendapatkan sertifikat Halal dari MUI, sehingga air yang tersimpan bebas dari segala kotoran maupun najis.
Sekarang ini sudah tersedia berbagai pilihan toren dengan kualitas terbaik dan menarik. Oleh karena itu, untuk informasi selengkapnya bisa langsung kunjungi marketplace rumah toren dan hubungi Whatsapp yang tertera berikut ini.






